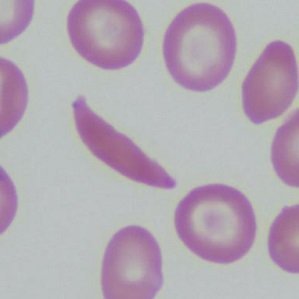

A new study by the CDC’s Sickle Cell Data Collection Program has found that mothers of newborns with sickle cell disease are more likely to live in socially vulnerable counties. The study, which analyzed data from 11 states between 2016 and 2020, identified 3,305 cases of sickle cell disease among newborns.
Lead author Dr. Mary Kayle and her colleagues found that 31% of mothers of affected newborns lived in counties with the highest levels of social vulnerability, compared to just 17% in the least vulnerable counties. Social vulnerability was assessed using the CDC’s Social Vulnerability Index, which considers factors such as poverty, lack of access to transportation, and crowded housing.
The study also revealed racial disparities, with sickle cell disease disproportionately affecting non-Hispanic Black newborns. However, missing data limited the researchers’ ability to fully examine differences across racial and ethnic groups.
Dr. Karen Remley, CEO of the American Academy of Pediatrics, emphasized the importance of addressing social determinants of health in sickle cell disease management. “This study highlights the need for comprehensive care that goes beyond medical treatment and considers the social and environmental factors impacting these families,” Remley said.
The findings underscore the importance of targeted interventions and resources for communities with high social vulnerability to improve outcomes for children born with sickle cell disease and their families.
“Birth Prevalence of Sickle Cell Disease and County-Level Social Vulnerability — Sickle Cell Data Collection Program, 11 States, 2016–2020” (March 28, 2024)